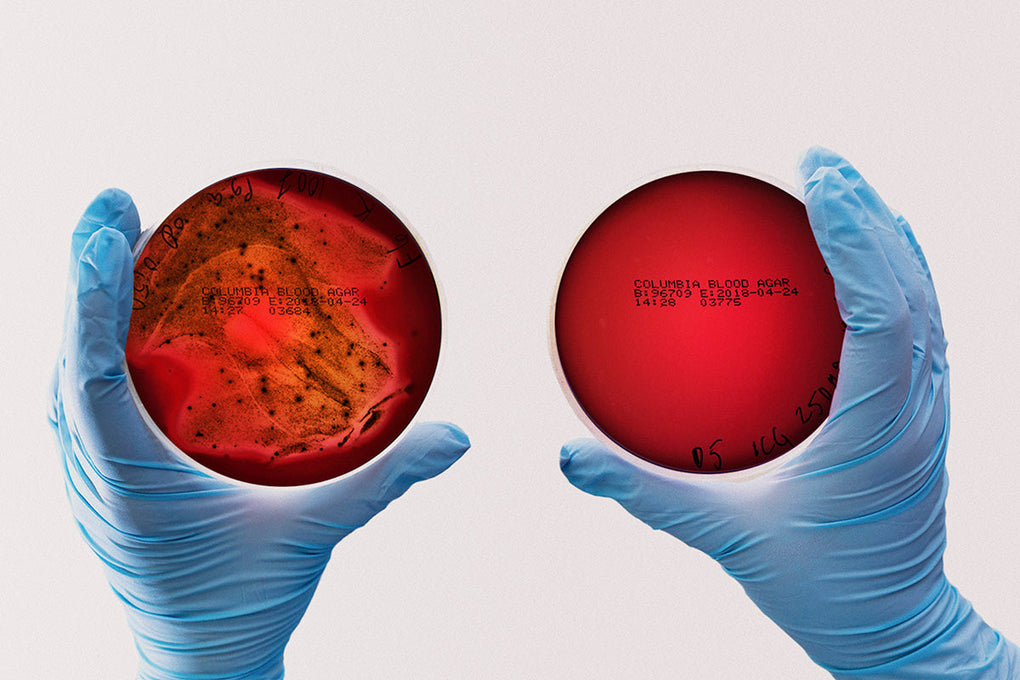

La storia di Lumoral
L'innovazione di Lumoral, basata sulla doppia fototerapia, ha rivoluzionato la cura dentale preventiva. In questo video, il cardiochirurgo Tommi Pätilä spiega come è nata l'innovazione Lumoral.
La missione del cardiochirurgo
Nel 2016, il cardiochirurgo Tommi Pätilä operò una grave infezione cardiaca presso l'Helsinki University Hospital (HUS) in Finlandia. Si scoprì che la causa principale del problema erano i batteri originati dalla bocca. Pätilä comprese che qualcosa doveva essere fatto. Non voleva mai più dover operare su un cuore che soffriva a causa di batteri orali.
I batteri della placca sono responsabili del 95% delle malattie dentali. Uno spazzolino da denti è uno strumento efficace per combattere la placca, tuttavia, anche il miglior spazzolino disponibile sul mercato, ne rimuove solo il 65%. Pätilä era determinato a trovare una soluzione: bisognava fare qualcosa per la placca residua.

Incontro significativo
Più o meno nello stesso periodo, Pätilä incontrò per caso Sakari Nikinmaa, un ingegnere impegnato nel progetto di Biodesign presso l'ospedale pediatrico. Nikinmaa era alla ricerca di un nuovo progetto interessante e si interessò alle scoperte di Pätilä. Insieme a Nikinmaa e al team di Biodesign, hanno deciso di mettersi in gioco e creare un laboratorio di ricerca presso la Aalto University. Sono iniziati ampi studi tecnici e antibatterici.

Il Team Fondatore
Il gruppo ha invitato alcuni dei massimi esperti mondiali di fisica, chimica e odontoiatria. La migliore competenza mondiale è stata trovata anche nel campo della tecnologia. Juha Rantala, con sede in Asia, un abile chimico dei semiconduttori, si unì al gruppo. Rantala ha una profonda familiarità con l'uso della luce blu antibatterica. L'esperienza di Saija Perovuo, analista di laboratorio presso il Dipartimento di Malattie Orali e Maxillofacciali, è stata fondamentale per lo sviluppo di Lumoral.

L'innovazione
Numerosi studi hanno scoperto che l'aPDT non è sufficiente e deve essere supportato da una luce blu antibatterica. Rantala ha progettato e implementato con cura i componenti LED per produrre due diverse lunghezze d'onda, il che ha permesso al team di andare avanti. Dopo migliaia di test, i parametri sono stati fatti funzionare e finalmente è stato progettato un metodo concreto, Lumoral, con Harri Koskinen responsabile del design.

Iniziano le sperimentazioni cliniche
Sotto la guida del professor Timo Sorsa, sono stati avviati studi clinici su larga scala in tutta Europa. Negli studi clinici, Lumoral si è dimostrato imbattibile. In studi randomizzati, la regolare inattivazione del biofilm ha avuto un effetto significativo nel trattamento della parodontite, una grave infezione gengivale. La malattia parodontale è stata tradizionalmente difficile da trattare, quindi l'aggiunta di recente scoperta al trattamento è un notevole passo avanti per le cure dentistiche.
Successo internazionale
Lumoral ha suscitato un diffuso interesse internazionale. Mentre la carie è la malattia più comune al mondo e l'infiammazione dei tessuti di sostegno dei denti è la sesta malattia più comune al mondo, la comunità medica fatica a trovarenuove soluzioni per combattere queste infezioni.
Il trattamento Lumoral ha mostrato il potenziale beneficio su diversi gruppi di pazienti con condizioni difficili da trattare. Il team continua i suoi sforzi scientifici con studi in corso nelle comunità accademiche di tutto il mondo.
